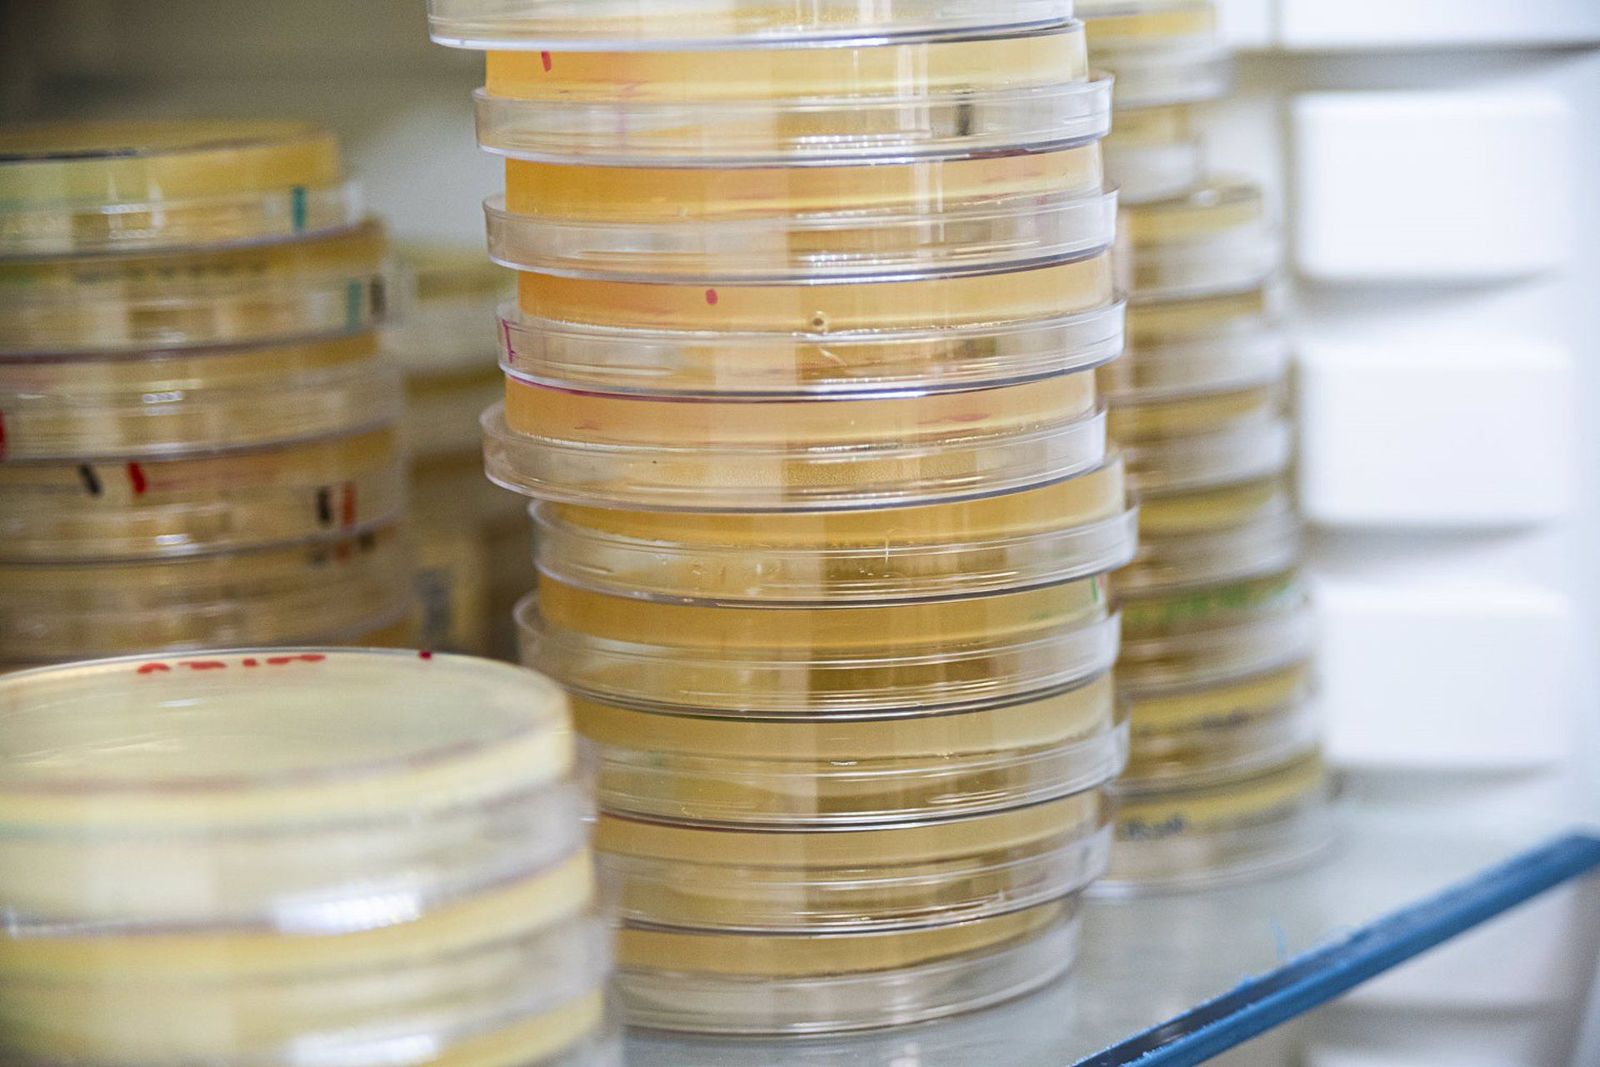
Placas de cultivos bacterianas de uso general en el laboratorio. EP

Descubren un nuevo mecanismo que favorece la resistencia a antibióticos en bacterias
Al desvelar los mecanismos moleculares que subyacen a este fenómeno, los científicos se acercan un paso más a encontrar soluciones para combatir una de las mayores amenazas para la salud
Un equipo de investigadores liderado por el Consejo Superior de Investigaciones Científicas (CSIC) ha dado un paso crucial en la comprensión de cómo las bacterias desarrollan resistencia a los antibióticos. En un estudio publicado en 'Nature Communications', los científicos han descrito un nuevo mecanismo molecular que permite a las bacterias manipular sus propios genes para favorecer la supervivencia y la propagación de genes de resistencia, presentes en elementos genéticos móviles como los plásmidos.
Este hallazgo revela una compleja interacción entre los plásmidos, pequeños fragmentos de ADN que se pueden transferir entre bacterias, y los cromosomas bacterianos. Los investigadores han demostrado que la presencia de un plásmido puede desencadenar una cascada de cambios en la expresión de los genes bacterianos, lo que permite a la bacteria adaptarse a las nuevas condiciones impuestas por el plásmido y, por tanto, favorecer la propagación de los genes de resistencia.
¿Por qué es importante este descubrimiento?
La resistencia a los antibióticos es una de las mayores amenazas para la salud pública a nivel mundial. El uso indiscriminado de antibióticos ha favorecido la aparición de bacterias cada vez más resistentes, lo que dificulta el tratamiento de infecciones comunes y complica el desarrollo de nuevos fármacos.
Este nuevo estudio proporciona una visión más profunda de los mecanismos moleculares que subyacen a la resistencia a los antibióticos, lo que podría allanar el camino hacia el desarrollo de nuevas estrategias para combatir este problema. Al comprender cómo las bacterias se vuelven resistentes, los científicos pueden diseñar terapias más efectivas y prevenir la propagación de genes de resistencia.
¿Cuáles son las implicaciones de este hallazgo?
Los resultados de esta investigación subrayan la importancia de realizar estudios básicos sobre la evolución de la resistencia a los antibióticos. Al comprender los mecanismos fundamentales que permiten a las bacterias adaptarse y sobrevivir, los científicos pueden desarrollar nuevas herramientas para combatir la resistencia a los antibióticos y preservar la eficacia de estos fármacos esenciales.
Además, este estudio destaca la necesidad de adoptar un enfoque multidisciplinario en la investigación sobre la resistencia a los antibióticos, combinando técnicas de biología molecular, genética y bioinformática.
También te puede interesar
Lo último








